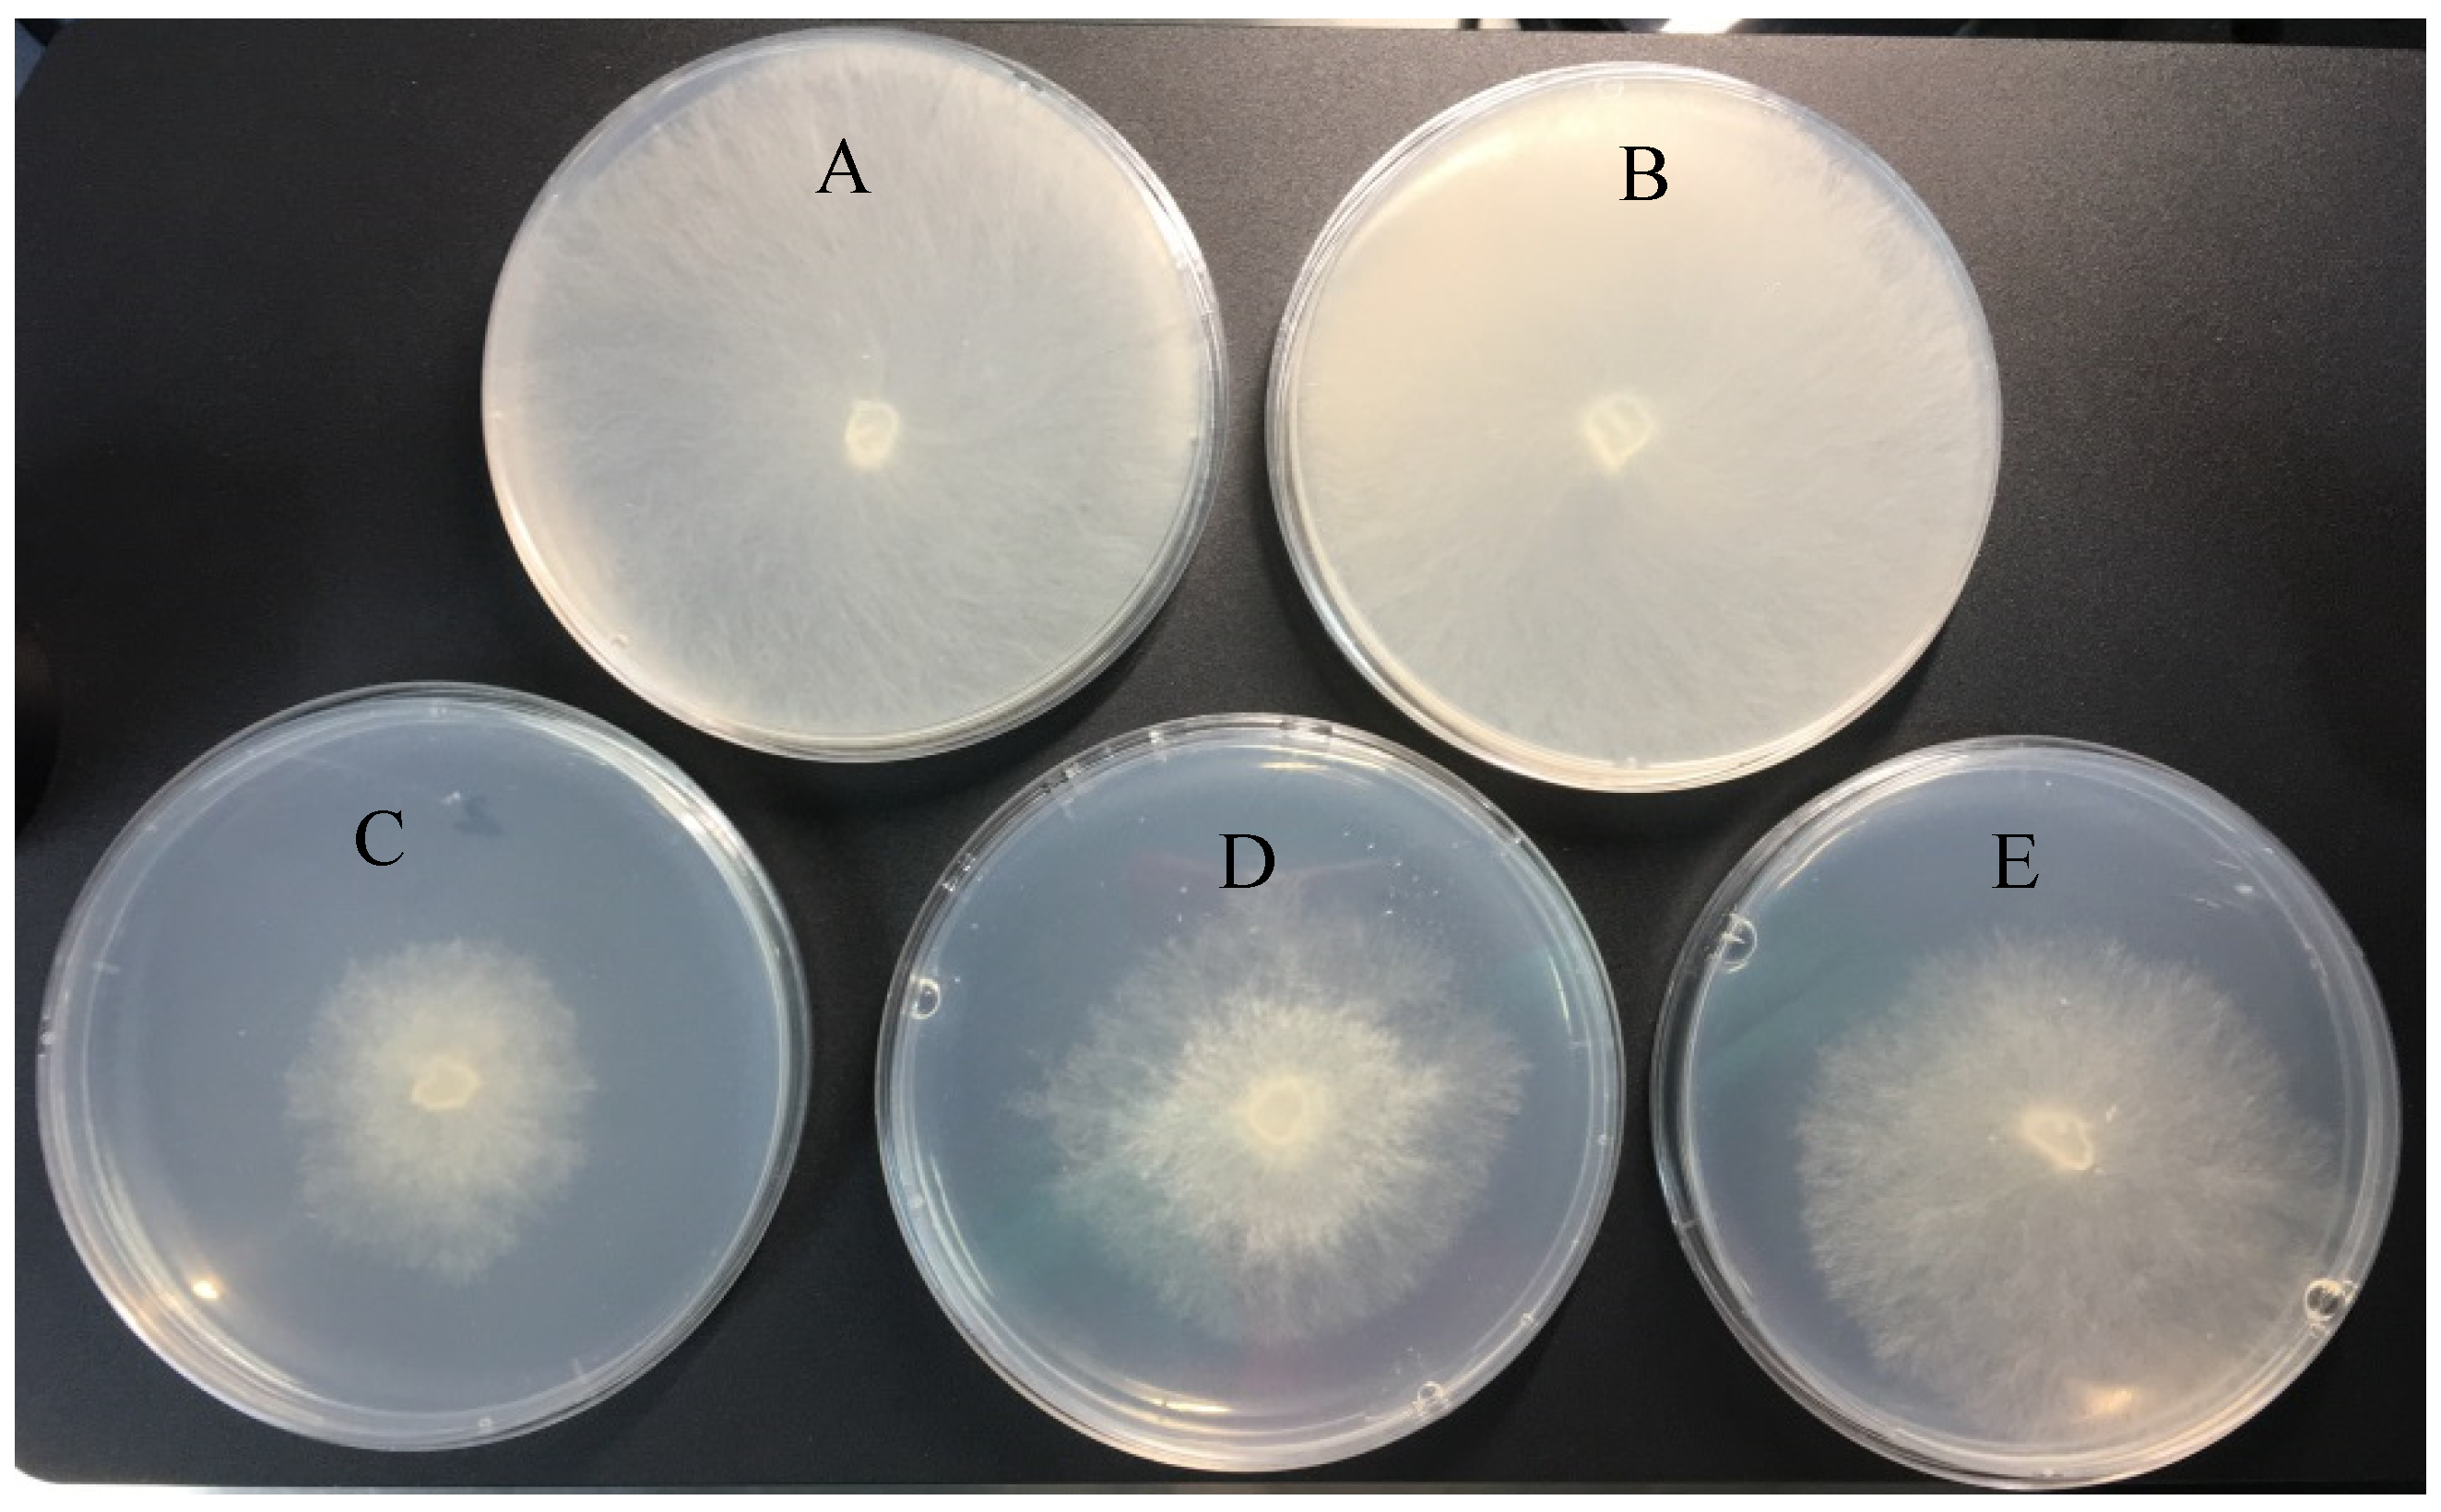
Pharmaceuticals 18 00780 g002

Difenoconazole-Loaded Nanostructured Lipid Carriers: Preparation, Characterization, and Evaluation
Abstract
1. Introduction
2. Results and Discussion
2.1. Selection of Lipid Materials
2.2. Characteristics of DFC-NLC Dispersions
2.3. Antifungal Activity of DFC-NLC Dispersions
2.4. Pathogen Uptakes of FITC-Labeled NLCs
2.5. Toxicity of DFC-NLC Dispersions
2.5.1. Acute Toxicity
2.5.2. Developmental Toxicity
3. Materials and Methods
3.1. Materials
3.1.1. Chemicals and Reagents
3.1.2. Biological Materials
3.2. Preparation of DFC-NLC Dispersions
3.3. Particle Size and Zeta Potential Measurements
3.4. TEM Observation
3.5. Drug Entrapment Efficiency and Drug Loading Determination
3.5.1. HPLC-MS/MS Analysis
3.5.2. Calculations
3.6. Antifungal Activity of DFC-NLC Dispersion
3.7. Targeting Dynamic Distributions
3.7.1. Synthesis of ODA-FITC
3.7.2. Preparation of FITC-Labeled DFC-NLC Dispersion
3.7.3. Pathogen Uptakes of FITC-Labeled DFC-NLCs
3.8. Safety Assessment
3.8.1. Acute Toxicity Assessment
3.8.2. Developmental Toxicity Assessment
3.9. Statistical Analyses
4. Conclusions
Author Contributions
Funding
Institutional Review Board Statement
Informed Consent Statement
Data Availability Statement
Conflicts of Interest
References
- Zheng, L.; Cao, C.; Chen, Z.; Cao, L.; Huang, Q.; Song, B. Efficient pesticide formulation and regulation mechanism for improving the deposition of droplets on the leaves of rice (Oryza sativa L.). Pest. Manag. Sci. 2021, 77, 3198–3207. [Google Scholar] [CrossRef] [PubMed]
- Ayilara, M.S.; Adeleke, B.S.; Akinola, S.A.; Fayose, C.A.; Adeyemi, U.T.; Gbadegesin, L.A.; Babalola, O.O. Biopesticides as a promising alternative to synthetic pesticides: A case for microbial pesticides, phytopesticides, and nanobiopesticides. Front. Microbiol. 2023, 14, 1040901. [Google Scholar] [CrossRef] [PubMed]
- Zhu, D.; Li, Y.; Liu, M.; Yang, Y.; Fu, J.; Su, L.; Wang, F.; Cen, Y.; Zhou, Y.; Li, Y. Study on the role of mitophagy and pyroptosis induced by nano-silver in testicular injury. Food Chem. Toxicol. 2025, 197, 115245. [Google Scholar] [CrossRef]
- Suhas, K.S.; Vijapure, S.; Yadav, S.; Ramesh, M.; Saminathan, M.; Jambagi, K.; Suresh, B.; Madhu, C.L.; Kumar, A.; Chandra, V.; et al. Nano-quercetin mitigates triazophos-induced testicular toxicity in rats by suppressing oxidative stress and apoptosis. Food Chem. Toxicol. 2024, 183, 114331. [Google Scholar] [CrossRef]
- Zhou, J.; Liu, G.; Guo, Z.; Wang, M.; Qi, C.; Chen, G.; Huang, X.; Yan, S.; Xu, D. Stimuli-responsive pesticide carriers based on porous nanomaterials: A review. Chem. Eng. J. 2023, 455, 140167. [Google Scholar] [CrossRef]
- Arcot, Y.; Mu, M.; Iepure, M.; Yodong, R.K.; Zhou, W.; Min, Y.; Cisneros-Zevallos, L.; Akbulut, M.E.S. Influence of nanopesticide surface chemistry on adsorption to plant cuticle and wax layer: The role of zeta potential and wetting. Surf. Interfaces 2024, 54, 105190. [Google Scholar] [CrossRef]
- Chaudhary, V.; Kumar, M.; Chauhan, C.; Sirohi, U.; Srivastav, A.L.; Rani, L. Strategies for mitigation of pesticides from the environment through alternative approaches: A review of recent developments and future prospects. J. Environ. Manag. 2024, 354, 120326. [Google Scholar] [CrossRef] [PubMed]
- Dong, J.; Li, H.; Wang, G.; Li, H.; Zhao, Y.; Li, X.; Xu, L.; Zhou, F.; Liu, R. Construction of pyrethrin nanopesticides based on zeolite Imidazole-8 framework via one-pot method for effectively wheat aphid control. Ind. Crops Prod. 2025, 224, 120424. [Google Scholar] [CrossRef]
- Gan, W.; Kong, X.; Fang, J.; Shi, X.; Zhang, S.; Li, Y.; Qu, L.; Liu, F.; Zhang, Z.; Zhang, F.; et al. A pH-responsive fluorescent nanopesticide for selective delivery and visualization in pine wood nematode control. Chem. Eng. J. 2023, 463, 142353. [Google Scholar] [CrossRef]
- Gupta, R.; Malik, P.; Rani, R.; Solanki, R.; Ameta, R.K.; Malik, V.; Mukherjee, T.K. Recent progress on nanoemulsions mediated pesticides delivery: Insights for agricultural sustainability. Plant Nano Biol. 2024, 8, 100073. [Google Scholar] [CrossRef]
- Zhang, H.; Zhang, Y.; Cao, C.; Zhao, P.; Huang, Q.; Cao, L. Optimization and characterization of pyraclostrobin nanoemulsion for pesticide delivery: Improving activity, reducing toxicity, and protecting ecological environment. Colloids Surf. A 2024, 692, 134051. [Google Scholar] [CrossRef]
- Li, L.; Cen, J.; Huang, L.; Luo, L.; Jiang, G. Fabrication of a dual pH-responsive and photothermal microcapsule pesticide delivery system for controlled release of pesticides. Pest. Manag. Sci. 2023, 79, 969–979. [Google Scholar] [CrossRef] [PubMed]
- Tao, R.; You, C.; Qu, Q.; Zhang, X.; Deng, Y.; Ma, W.; Huang, C. Recent advances in the design of controlled- and sustained-release micro/nanocarriers of pesticide. Environ. Sci. Nano 2023, 10, 351–371. [Google Scholar] [CrossRef]
- Jin, X.; Xiao, R.; Cao, Z.; Du, X. Smart controlled-release nanopesticides based on metal–organic frameworks. Chem. Commun. 2024, 60, 6082–6092. [Google Scholar] [CrossRef]
- Liu, J.; Xu, D.; Xu, G.; Li, X.; Dong, J.; Luan, X.; Du, X. Smart controlled-release avermectin nanopesticides based on metal–organic frameworks with large pores for enhanced insecticidal efficacy. Chem. Eng. J. 2023, 475, 146312. [Google Scholar] [CrossRef]
- Krumova, E.; Benkova, D.; Stoyancheva, G.; Dishliyska, V.; Miteva-Staleva, J.; Kostadinova, A.; Ivanov, K.; El-sayed, K.; Staneva, G.; Elshoky, H.A. Exploring the mechanism underlying the antifungal activity of chitosan-based ZnO, CuO, and SiO2 nanocomposites as nanopesticides against Fusarium solani and Alternaria solani. Int. J. Biol. Macromol. 2024, 268, 131702. [Google Scholar] [CrossRef]
- Ly, N.H.; Nguyen, N.B.; Tran, H.N.; Hoang, T.T.H.; Joo, S.-W.; Vasseghian, Y.; Kamyab, H.; Chelliapan, S.; Klemeš, J.J. Metal-organic framework nanopesticide carrier for accurate pesticide delivery and decrement of groundwater pollution. J. Clean. Prod. 2023, 402, 136809. [Google Scholar] [CrossRef]
- Sułowicz, S.; Borymski, S.; Dulski, M.; Nowak, A.; Markowicz, A. Functional gene array and non-target soil microorganisms in nanopesticides captan@ZnO 35–45 nm and captan@SiO2 20–30 nm environmental risk assessment. Chemosphere 2025, 377, 144347. [Google Scholar] [CrossRef]
- Xu, X.; Qiu, H.; Van Gestel, C.A.M.; Gong, B.; He, E. Impact of nanopesticide CuO-NPs and nanofertilizer CeO2-NPs on wheat Triticum aestivum under global warming scenarios. Chemosphere 2023, 328, 138576. [Google Scholar] [CrossRef]
- Chen, H.; Yang, L.; Zhao, S.; Xu, H.; Zhang, Z. Long-term toxic effects of iron-based metal-organic framework nanopesticides on earthworm-soil microorganism interactions in the soil environment. Sci. Total Environ. 2024, 917, 170146. [Google Scholar] [CrossRef]
- Kah, M.; Kookana, R.S.; Gogos, A.; Bucheli, T.D. A critical evaluation of nanopesticides and nanofertilizers against their conventional analogues. Nat. Nanotechnol. 2018, 13, 677–684. [Google Scholar] [CrossRef] [PubMed]
- Ye, X.X.; Li, H.Y.; Wang, Q.Y.; Chai, R.S.; Ma, C.; Gao, H.J.; Mao, J.D. Influence of aspartic acid and lysine on the uptake of gold nanoparticles in rice. Ecotox. Environ. Saf. 2018, 148, 418–425. [Google Scholar] [CrossRef] [PubMed]
- Ye, X.X.; Wang, G.Z.; Zhang, Y.X.; Zhao, H.J. Hydroxyapatite nanoparticles in root cells: Reducing the mobility and toxicity of Pb in rice. Environ. Sci. Nano 2018, 5, 398–407. [Google Scholar] [CrossRef]
- Chinnaperumal, K.; Govindasamy, B.; Paramasivam, D.; Dilipkumar, A.; Dhayalan, A.; Vadivel, A.; Sengodan, K.; Pachiappana, P. Bio-pesticidal effects of Trichoderma viride formulated titanium dioxide nanoparticle and their physiological and biochemical changes on Helicoverpa armigera (Hub.). Pestic. Biochem. Physiol. 2018, 149, 26–36. [Google Scholar] [CrossRef] [PubMed]
- Su, Y.M.; Ashworth, V.; Kim, C.; Adeleye, A.S.; Rolshausen, P.; Roper, C.; White, J.; Jassby, D. Delivery, uptake, fate, and transport of engineered nanoparticles in plants: A critical review and data analysis. Environ. Sci. Nano 2019, 6, 2311–2331. [Google Scholar] [CrossRef]
- Yu, M.L.; Sun, C.J.; Xue, Y.M.; Liu, C.; Qiu, D.W.; Cui, B.; Zhang, Y.; Cui, H.X.; Zeng, Z.H. Tannic acid-based nanopesticides coating with highly improved foliage adhesion to enhance foliar retention. RSC Adv. 2019, 9, 27096–27104. [Google Scholar] [CrossRef]
- Zhao, K.F.; Hu, J.; Ma, Y.; Wu, T.Y.; Gao, Y.X.; Du, F.P. Topology-regulated pesticide retention on plant leaves through concave Janus carriers. ACS Sustain. Chem. Eng. 2019, 7, 13148–13156. [Google Scholar] [CrossRef]
- Huang, B.N.; Chen, F.F.; Shen, Y.; Qian, K.; Wang, Y.; Sun, C.J.; Zhao, X.; Cui, B.; Gao, F.; Zeng, Z.H.; et al. Advances in targeted pesticides with environmentally responsive controlled release by nanotechnology. Nanomaterials 2018, 8, 102. [Google Scholar] [CrossRef]
- Xiang, Y.B.; Zhang, G.L.; Chen, C.W.; Liu, B.; Cai, D.Q.; Wu, Z.Y. Fabrication of a pH-responsively controlled-release pesticide using an attapulgite-based hydrogel. ACS Sustain. Chem. Eng. 2018, 6, 1192–1201. [Google Scholar] [CrossRef]
- Zhao, P.Y.; Yuan, W.L.; Xu, C.L.; Li, F.M.; Cao, L.D.; Huang, Q.L. Enhancement of spirotetramat transfer in cucumber plant using mesoporous silica nanoparticles as carriers. J. Agric. Food Chem. 2018, 66, 11592–11600. [Google Scholar] [CrossRef]
- Zhang, Y.; Zhao, J.R.; Sun, X.B.; Pan, W.; Yu, G.F.; Wang, J.P. Fluorescent carbon dots for probing the effect of thiram on the membrane of fungal cell and its quantitative detection in aqueous solution. Sens. Actuators B Chem. 2018, 273, 1833–1842. [Google Scholar] [CrossRef]
- Vyavhare, S.S.; Way, M.O.; Pearson, R.A.; Groth, D.E. Interactive impacts of rice water weevil1 and sheath blight pathogen on rice yield. Southwest. Entomolog. 2019, 44, 363–372. [Google Scholar] [CrossRef]
- Gill, U.S.; Lee, S.; Jia, Y.L.; Mysore, K.S. Exploring natural variation for rice sheath blight resistance in Brachypodium distachyon. Plant Signal. Behav. 2019, 14, 1559–2324. [Google Scholar] [CrossRef] [PubMed]
- Zhang, B.H.; Lu, F.S.; Wang, J. Optimization of difenoconazole suspension concentrates formulation with orthogonal method. Adv. Mater. Res. 2013, 638, 412–415. [Google Scholar] [CrossRef]
- Zhang, B.H.; Lu, F.S.; Liao, K.C.; Li, P.Q. Effect of sodium alginate on the rheological properties of difenoconazole suspension concentrates. J. Food Agric. Environ. 2013, 11, 553–556. [Google Scholar]
- Cao, C.; Zhou, Z.L.; Cao, L.D.; Zheng, L.; Xu, J.; Li, F.M.; Huang, Q.L. Influence of the surface limiting elasticity modulus on the impact behavior of droplets of difenoconazole-loaded mesoporous silica nanoparticles with associated SDS. Soft Matter 2018, 14, 6070–6075. [Google Scholar] [CrossRef]
- Raghunath, I.; Koland, M.; Sarathchandran, C.; Saoji, S.; Rarokar, N. Design and optimization of chitosan-coated solid lipid nanoparticles containing insulin for improved intestinal permeability using piperine. Int. J. Biol. Macromol. 2024, 280, 135849. [Google Scholar] [CrossRef]
- Patil, J.; Bhattacharya, S.; Saoji, S.D.; Dande, P. Cabozantinib-phospholipid complex for enhanced solubility, bioavailability, and reduced toxicity in liver cancer. Ther. Deliv. 2025, 16, 25–41. [Google Scholar] [CrossRef] [PubMed]
- Shaikh, R.; Bhattacharya, S.; Saoji, S.D. Development, optimization, and characterization of polymeric micelles to improve dasatinib oral bioavailability: Hep G2 cell cytotoxicity and in vivo pharmacokinetics for targeted liver cancer therapy. Heliyon 2024, 10, 39632. [Google Scholar] [CrossRef]
- Parisa, G.; Soliman, M. Solid lipid nanoparticles and nanostructured lipid carriers as novel drug delivery systems: Applications, advantages and disadvantages. Res. Pharm. Sci. 2018, 13, 288–303. [Google Scholar]
- Vanti, G.; Muti, L.; D’Ambrosio, M.; Grifoni, L.; Bergonzi, M.C.; Luceri, C.; Bilia, A.R. Nanostructured lipid carriers can enhance oral absorption of Khellin, a natural pleiotropic molecule. Molecules 2021, 26, 7657. [Google Scholar] [CrossRef] [PubMed]
- Nguyen, V.H.; Thuy, V.N.; Van, T.V.; Dao, A.H.; Lee, B.J. Nanostructured lipid carriers and their potential applications for versatile drug delivery via oral administration. OpenNano 2022, 8, 100064. [Google Scholar] [CrossRef]
- Jia, B.; Li, S.; Li, L.; Wang, T.; Chen, W.; Chen, G. Nanostructured lipid carriers loaded with morellic acid for enhanced anticancer efficacy: Preparation, characterization, pharmacokinetics and anticancer evaluation. Am. J. Cancer Res. 2024, 14, 1101–1120. [Google Scholar] [CrossRef]
- Shirazi, A.S.; Varshochian, R.; Rezaei, M.; Ardakani, Y.H.; Dinarvand, R. SN38 loaded nanostructured lipid carriers (NLCs); preparation and in vitro evaluations against glioblastoma. J. Mater. Sci. Mater. M 2021, 32, 78. [Google Scholar] [CrossRef]
- Yoozbashi, M.; Rashidzadeh, H.; Kermanian, M.; Sadighian, S.; Hosseini, M.J.; Kaboli, Z.; Rostamizadeh, K. Magnetic nanostructured lipid carrier for dual triggered curcumin delivery: Preparation, characterization and toxicity evaluation on isolated rat liver mitochondria. J. Biomater. Appl. 2022, 36, 1055–1063. [Google Scholar] [CrossRef]
- Morakul, B.; Junyaprasert, V.B.; Sakchaisri, K.; Teeranachaideekul, V. Cannabidiol-loaded nanostructured lipid carriers (NLCs) for dermal delivery: Enhancement of photostability, cell viability, and anti-inflammatory activity. Pharmaceutics 2023, 15, 537. [Google Scholar] [CrossRef] [PubMed]
- Chai, G.H.; Hu, F.Q.; Sun, J.; Du, Y.Z.; You, J.; Yuan, H. Transport pathways of solid lipid nanoparticles across Madin-Darby canine kidney epithelial cell monolayer. Mol. Pharm. 2014, 11, 3716–3726. [Google Scholar] [CrossRef]
- Mendes, A.I.; Silva, A.C.; Catita, J.A.M.; Cerqueira, F.; Gabriel, C.; Lopes, C.M. Miconazole-loaded nanostructured lipid carriers (NLC) for local delivery to the oral mucosa: Improving antifungal activity. Colloids Surf. B 2013, 111, 755–763. [Google Scholar] [CrossRef] [PubMed]
- Abdelrahman, T.M.; Qin, X.Y.; Li, D.L.; Senosy, I.A.; Mmby, M.; Wan, H.; Li, J.; He, S. Pectinase-responsive carriers based on mesoporous silica nanoparticles for improving the translocation and fungicidal activity of prochloraz in rice plants. Chem. Eng. J. 2021, 404, 126440. [Google Scholar] [CrossRef]
- Liang, Y.; Fan, C.; Dong, H.Q.; Zhang, W.B.; Tang, G.; Yang, J.L.; Jiang, N.; Cao, Y.S. Preparation of MSNs-Chitosan@Prochloraz Nanoparticles for Reducing Toxicity and Improving Release Properties of Prochloraz. ACS Sustain. Chem. Eng. 2018, 6, 10211–10220. [Google Scholar] [CrossRef]
- Guo, Q.; Zhang, S.; Shao, Y.; Guo, C.; Yang, Y.; Liu, Z. Preparation and in vitro evaluation of reduction-responsive targeting self-loaded nanoparticle. Chin. J. Mod. Appl. Pharm. 2022, 39, 2511–2520. [Google Scholar]
- de Oliveira, J.L.; Ramos Campos, E.V.; Bakshi, M.; Abhilash, P.C.; Fraceto, L.F. Application of nanotechnology for the encapsulation of botanical insecticides for sustainable agriculture: Prospects and promises. Biotechnol. Adv. 2014, 32, 1550–1561. [Google Scholar] [CrossRef] [PubMed]
- Jiang, T.S.; Qi, S.Z.; Zhu, C.H.; Zhao, H.Q.; Duan, L.S. Reducing pesticide use: Synthesis and application of ROS-SPC as an efficient nanocarrier and scavenger of reactive oxygen species in plants. Adv. Agrochem 2024, 3, 162–170. [Google Scholar] [CrossRef]
- Shao, X.R.; Wei, X.Q.; Song, X.; Hao, L.Y.; Cai, X.X.; Zhang, Z.R.; Peng, Q.; Lin, Y.F. Independent effect of polymeric nanoparticle zeta potential/surface charge, ontheir cytotoxicity and affinity to cells. Cell Prolif. 2015, 48, 465–474. [Google Scholar] [CrossRef]
- Pasquoto-Stigliani, T.; Campos, E.V.R.; Oliveira, J.L.; Silva, C.M.G.; Bilesky-Jose, N.; Guilger, M.; Troost, J.; Oliveira, H.C.; Stolf-Moreira, R.; Fraceto, L.F.; et al. Nanocapsules Containing Neem (Azadirachta indica) Oil: Development, Characterization, And Toxicity Evaluation. Sci. Rep. 2017, 7, 5929. [Google Scholar] [CrossRef]
- An, C.C.; Huang, B.N.; Jiang, J.J.; Wang, X.Y.; Li, N.J.; Liu, H.H.; Shen, Y.; Sun, C.J.; Zhan, S.S.; Li, X.Y.; et al. Design and synthesis of a water-based nanodelivery pesticide system for improved efficacy and safety. ACS Nano 2023, 18, 662–679. [Google Scholar] [CrossRef]
- Miao, J.; Du, Y.Z.; Yuan, H.; Zhang, X.G.; Hu, F.Q. Drug resistance reversal activity of anticancer drug loaded solid lipid nanoparticles in multi-drug resistant cancer cells. Colloids Surf. B 2013, 110, 74–80. [Google Scholar] [CrossRef]
- Miao, J.; Du, Y.; Yuan, H.; Zhang, X.; Li, Q.; Rao, Y.; Zhao, M.; Hu, F. Improved cytotoxicity of paclitaxel loaded in nanosized lipid carriers by intracellular delivery. J. Nanopart. Res. 2015, 17, 10. [Google Scholar] [CrossRef]
- Guo, S.Y.; Zhang, Y.; Zhu, X.Y.; Zhou, J.L.; Li, J.; Li, C.Q.; Wu, L.R. Developmental neurotoxicity and toxic mechanisms induced by olaquindox in zebrafish. J. Appl. Toxicol. 2021, 41, 549–560. [Google Scholar] [CrossRef] [PubMed]
- Xue, X.R.; Zhang, Z.Q.; Yang, Y.; Hu, L.; Zhao, M.Y.; He, Q.N. Acute exposure of perchlorate on zebrafish larvae: Neurotoxicity during development. Ecotoxicol. Environ. Saf. 2025, 294, 118111. [Google Scholar] [CrossRef]

| Solid Lipid | Liquid Lipid | Average Diameter (nm) | Polydispersity Index | Zeta Potential (mv) | Short-Term Laboratory Storage Stability |
|---|---|---|---|---|---|
| Monostearin | Oleic acid | 201.0 ± 2.0 | 0.21 ± 0.05 | −22.1 ± 0.5 | Keep stable |
| Stearic acid | Oleic acid | 212.3 ± 2.7 | 0.35 ± 0.08 | −15.4 ± 0.4 | Tend to coagulate or flocculate |
| Tristearin | Oleic acid | 176.1 ± 3.4 | 0.29 ± 0.06 | −18.6 ± 0.3 | |
| Behenic acid glyceride | Oleic acid | 180.6 ± 3.2 | 0.30 ± 0.05 | −17.9 ± 0.3 |
| Monostearin Proportion (%) | Oleic Acid Proportion (%) | Average Diameter (nm) | Polydispersity Index | Zeta Potential (mv) | Entrapment Efficiency (%) | Drug Loading (%) |
|---|---|---|---|---|---|---|
| 90 | 10 | 201.0 ± 3.2 | 0.20 ± 0.05 | −22.1 ± 0.2 | 69.1 ± 1.8 | 7.1 ± 0.3 |
| 80 | 20 | 198.3 ± 2.6 | 0.20 ± 0.04 | −23.4 ± 0.4 | 78.9 ± 2.3 | 8.1 ± 0.5 |
| 70 | 30 | 176.1 ± 2.8 | 0.18 ± 0.06 | −25.3 ± 0.3 | 95.0 ± 2.6 | 9.7 ± 0.6 |
| Samples | Regression Equation | R2 | EC50 (mg·L−1) | 95% Confidence Limits (mg·L−1) |
|---|---|---|---|---|
| DFC-NLC | Y = 6.0510 + 1.0823 X | 0.9367 | 0.107 a | 0.0677~0.1688 |
| DFC-EC | Y = 5.7140 + 1.0574 X | 0.9878 | 0.211 b | 0.1721~0.2593 |
| DFC-SC | Y = 5.5351 + 1.0838 X | 0.9791 | 0.321 b | 0.2364~0.4353 |
| Group | Concentration (mg·L−1) | Number of Deaths (Individuals) | Mortality Percentage (%) |
|---|---|---|---|
| Control | - | 0 | 0 |
| DFC-NLC | 5.00 | 0 | 0 |
| 6.25 | 5 | 17 | |
| 7.50 | 30 | 100 | |
| 8.75 | 30 | 100 | |
| 10.0 | 30 | 100 | |
| DFC-EC | 1.25 | 0 | 0 |
| 2.50 | 0 | 0 | |
| 5.00 | 10 | 33 | |
| 10.0 | 30 | 100 | |
| 20.0 | 30 | 100 | |
| DFC-SC | 1.25 | 0 | 0 |
| 2.50 | 0 | 0 | |
| 5.00 | 18 | 60 | |
| 10.0 | 30 | 100 | |
| 20.0 | 30 | 100 |
| Type | Abnormality Percentages (%) | ||||
|---|---|---|---|---|---|
| Control | DFC-NLC | DFC-EC | DFC-SC | ||
| Heart | Pericardial edema | - | - | - | - |
| Arrhythmia | - | 33a | 93b | 100b | |
| Circulatory system | Accelerated blood flow | - | - | - | - |
| Slowed blood flow/Absence | - | 33a | 93b | 100b | |
| Hemorrhage/Thrombosis | - | - | - | - | |
| Brain | Degeneration | - | - | - | - |
| Reduction | - | - | - | - | |
| Jaw | Malformation | - | 47a | 93b | 100b |
| Eyes | Reduction | - | 90 | 100 | 100 |
| Liver | Enlargement | - | - | - | - |
| Reduction/Absence | - | 30a | 63b | 77b | |
| Degeneration | - | - | - | - | |
| Yolk sac absorption delay | - | 100 | 100 | 100 | |
| Kidneys | Pronephric edema | - | - | - | - |
| Intestine | Deformity | - | -a | 10a | 57b |
| Trunk/Tail/ Notochord | Curvature | - | -a | 47b | 90c |
| Edema | - | - | - | - | |
| Fins | Absence | - | - | - | - |
| Body length | Decrease | - | 80a | 100b | 100b |
| Behaviors | Abnormality | - | 10a | 60b | 100c |
| Muscle | Muscle degeneration | - | - | - | - |
| Body pigmentation | - | - | - | - | |
| Otic vesicles | Reduction | - | 63a | 100b | 100b |
| Swim bladder | Loss | - | 97 | 100 | 100 |
| Compound | Parent Mass (m/z) | Product Mass (m/z) | Collision Energy (V) |
|---|---|---|---|
| DFC | 406 | 337 | 29 |
| 251 * | 25 |
Disclaimer/Publisher’s Note: The statements, opinions and data contained in all publications are solely those of the individual author(s) and contributor(s) and not of MDPI and/or the editor(s). MDPI and/or the editor(s) disclaim responsibility for any injury to people or property resulting from any ideas, methods, instructions or products referred to in the content. |
© 2025 by the authors. Licensee MDPI, Basel, Switzerland. This article is an open access article distributed under the terms and conditions of the Creative Commons Attribution (CC BY) license (https://creativecommons.org/licenses/by/4.0/).
Share and Cite
Li, Y.; Zhang, H.; Meng, T.; Zhou, Y.; Zhou, B.; Du, S.; Yuan, H.; Hu, F. Difenoconazole-Loaded Nanostructured Lipid Carriers: Preparation, Characterization, and Evaluation. Pharmaceuticals 2025, 18, 780. https://doi.org/10.3390/ph18060780
Li Y, Zhang H, Meng T, Zhou Y, Zhou B, Du S, Yuan H, Hu F. Difenoconazole-Loaded Nanostructured Lipid Carriers: Preparation, Characterization, and Evaluation. Pharmaceuticals. 2025; 18(6):780. https://doi.org/10.3390/ph18060780
Chicago/Turabian StyleLi, Yinghong, Hu Zhang, Tingting Meng, Yuqin Zhou, Beilei Zhou, Shihan Du, Hong Yuan, and Fuqiang Hu. 2025. "Difenoconazole-Loaded Nanostructured Lipid Carriers: Preparation, Characterization, and Evaluation" Pharmaceuticals 18, no. 6: 780. https://doi.org/10.3390/ph18060780
APA StyleLi, Y., Zhang, H., Meng, T., Zhou, Y., Zhou, B., Du, S., Yuan, H., & Hu, F. (2025). Difenoconazole-Loaded Nanostructured Lipid Carriers: Preparation, Characterization, and Evaluation. Pharmaceuticals, 18(6), 780. https://doi.org/10.3390/ph18060780







